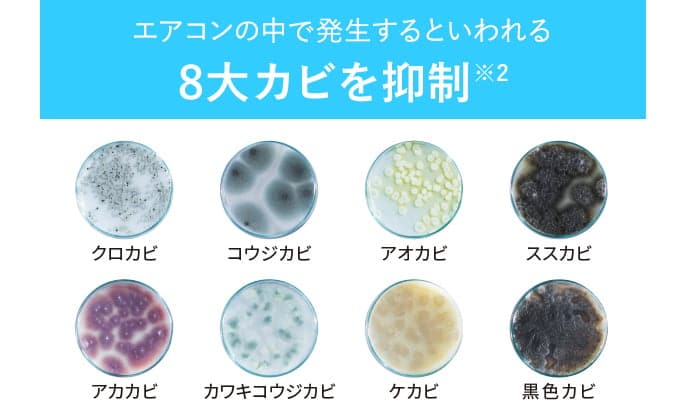
Máy lọc không khí Máy lọc không khí

Hỏi đáp cho bài viết này
Để có môi trường trong lành trong chính ngôi nhà của mình thì không thể thiếu máy lọc không khí. Cùng tham khảo bài viết dưới đây về 5 ưu điểm của máy lọc không khí nội địa Nhật Bản.
Sống trong thời đại công nghiệp phát triền, công trường xây dựng, xe cộ đi lại cũng nhiều hơn, cây xanh cũng bị giảm bớt thay thế cho các ngôi nhà cao tầng hay các tòa nhà chug cư. Khói bụi ô nhiễm rất nhiều và ở tại các thành phố lớn mức bụi báo động luôn là báo động đỏ. Để có môi trường trong lành thư dãn trong chính ngôi nhà của mình thì không thể thiếu chiếc máy lọc không khí trong gia đình. Ưu điểm của lọc không khí như thế nào?

1. Lọc không khí và lọc mùi
- Trong tất cả các máy lọc không khí nội địa Nhật Bản luôn được trang bị bộ ba màng lọc hepa và màng lọc thô, màng lọc than hoạt tính. Bộ 3 màng lọc kết hợp cùng quạt hút sẽ thu gom bụi và đẩy ra luông không khí sạch tươi mới. Màng lọc hoạt tính sẽ loại bỏ hoàn toàn mùi lạn trong phòng và mùi độc hại để trong phòng luôn thơm mát.


- Công nghệ Ion lpasma hoặc các hạt ion, và hạt nanoE. Tùy từng máy lọc không khí sẽ có các công nghệ khác nhau, xong các hạt này vẫn làm việc dựa theo nguyên lí, khi một luồng không khí trong phòng các hạt này được máy tạo ra và bay trong không khí trong phòng, nó sẽ phát hiện các bụi và không khí lạ để triệt tiêu nên phòng luôn có mùi thơm mát.


- Với các dòng máy lọc không khí nội địa Nhật Bản có thể xử lí hoàn toàn bụi từ vải hay bụi từ môi trường, lông chó mèo, các loại mùi nấu ăn, mùi thuốc lá, mùi hôi, mùi ẩm mốc…
- Máy lóc không khí nội địa Nhật Bản lọc được cả phấn hoa rất phù hợp cho những người bị dị ứng.

2. Chức năng bù ẩm
Nhiều người vẫn đang hiểu chức năng bù ẩm của máy lọc không khí sẽ giống như 1 chiếc máy phun sương phun hơi nước ra để tạo ẩm trong không khí. Nhưng thực tế máy lọc không khí nội địa Nhật sẽ bù ẩm bằng phân tử nước, trong máy được thiết kế 1 bình đựng nước và máy sẽ tự động bù ẩm.
Máy lọc không khí nội địa Nhật Bản được trang cảm biến độ ẩm, máy sẽ tự phát hiện độ ẩm trong phòng và chỉ bù khi độ ẩm thấp, việc bù ẩm bằng phân tử nước sẽ gúp việc bù ẩm được hiệu quả, không làm hại đến các thiết bị điện tử hay tường nhà do độ ẩm không được sử dụng hết.


3. Nhiều cảm biến thông minh
Được trang bị nhiều cảm biến thông minh, cảm biến bui, mùi, độ ẩm, ánh sáng, phấn hoa … như tự động phát hiện bụi bẩn, mùi, tự cảm biến độ ẩm, cảm biến ánh sáng giúp việc sử dụng mát rất tiện lợi. Máy sẽ tự lọc không khí khi thấy không khí bẩn, tự bù ẩm khi thấy khô, hay tự động chuyển về chế độ ngủ khi thấy đèn tắt giúp máy hoạt động trong trạng thái êm ái.
4. Tiết kiệm điện
Chỉ với công suất hoạt động là 36w đến 90w cho 1 chiếc máy lọc không khí đầy đủ tất cả các tính năng. Máy lọc không khí bạ có thể cắm và dùng liên tục 24/24 mà không lo tốn điện.
5. Thay thế đơn giản và bền bỉ
Các máy lọc không khí sẽ có hạn mức thay màng lọc sau nhiều năm sử dụng và thông thường các model mới máy lọc không khí màng lọc có tuổi thọ khoảng 10 năm như vậy có thể nó là rất lâu và việc thay thế cũng rất đơn giản.
Máy lọc không khí sẽ rất phù hợp với các gia đình sống tại các thành phố bị khói bụi nhiều, phù hợp với các trẻ em và trẻ sơ sinh, nhưng ai bị dị ứng phấn hoa và bị dị ứng thời tiết và bị viêm xoang thì sử dụng máy lọc không khí rất tốt.
Như vậy, có thế thấy máy lọc không khí nội địa Nhật rất tiện ích và thông minh, không quá khó hiểu về nguyên lí làm việc và cách xử lí công việc của một chiếc máy lọc không khí.
Mong rằng, với chia sẻ của Điện máy 123 giúp quý khách hiểu hơn về lọc không khí nội địa Nhật Bản và dễ dàng chọn muac chiếc lọc không khí ứng ý cho gia đình.